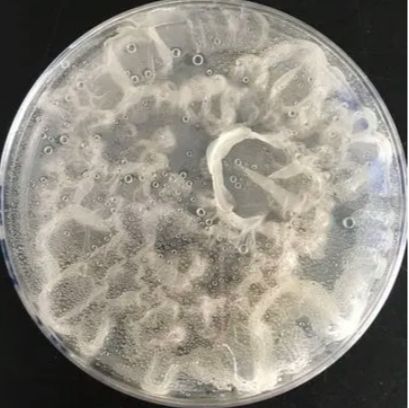
Botrytis Cinerea

Botrytis Cinerea
Botrytis Cinerea
询价
1株
起订
北京 更新日期:2026-04-17
产品详情:
- 中文名称:
- Botrytis Cinerea
- 英文名称:
- Botrytis Cinerea
- 品牌:
- 微生物菌种查询网
- 产地:
- 中国
- 保存条件:
- 2-8度
- 纯度规格:
- 99.99%
- 产品类别:
- 化工产品
- 别名:
- NRRL 1650
- 用途:
- 科研,分类
- 产品规格:
- 冻干粉/培养物
- 主要用途:
- 研究,教学
- 是否危险化学品:
- 否
- 货号:
- bio-137086
公司简介
中国微生物菌种查询网隶属于北京百欧博伟生物技术有限公司,成立于二〇一四年十月份,是一家专业提供中国微生物菌种,标准菌种,质控菌株,ATCC菌种,细胞系以及培养基等产品的查询网站!自成立至今,已提供各类微生物菌种、细胞、培养基数量达四万余份,接待咨询客户数量5万余人次,成交合同数量2万余份!是国内微生物菌种及细胞信息Z全的网站! 我们拥有自主研发能力,提供的ATCC菌种达15000余份,ATCC各类细胞系达3000余份,保藏中心涵盖菌种资源更达数十万余份!
除此之外,我们还拥有对菌种、细胞、培养基、配套试剂等产品需求者的极优质服务,对购买项目的前期资料提供,中期合同保证,后期货物跟踪到Z终售后的确保项目准确到位,都有相关人士进
| 成立日期 | (14年) |
| 注册资本 | 50 万人民币 |
| 员工人数 | 10-50人 |
| 年营业额 | ¥ 500万-1000万 |
| 经营模式 | 贸易,试剂,服务 |
| 主营行业 | 细胞培养,分子生物学,微生物学,细胞生物学 |
Botrytis Cinerea相关厂家报价 更多
-

- 葡萄孢菌LAMP试剂盒
- 上海雅吉生物科技有限公司 VIP
- 2026-04-18
- ¥3980
-

- 葡萄孢菌染料法荧光定量PCR试剂盒
- 上海泽叶生物科技有限公司 VIP
- 2026-04-17
- ¥2490
-

- 灰霉菌PCR试剂盒
- 上海康朗生物科技有限公司 VIP
- 2026-04-17
- ¥1490
-

- 灰霉菌PCR试剂盒 72882-27-0
- 上海晶风生物科技有限公司 VIP
- 2026-04-17
- ¥3490
-

- 葡萄孢菌染料法荧光定量PCR试剂盒
- 上海博湖生物科技有限公司 VIP
- 2026-04-17
- ¥3490
-

- Botrytis cinerea 葡萄孢菌染料法荧光定量PCR试剂盒 YB-71425DPR
- 上海钰博生物科技有限公司 VIP
- 2026-04-13
- ¥2990
-

- 葡萄孢菌荧光定量PCR试剂盒(探针法)
- 上海泽叶生物科技有限公司 VIP
- 2026-04-17
- ¥3490